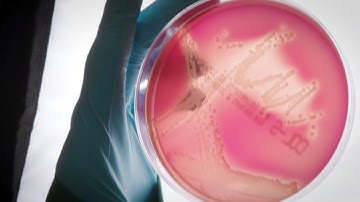
Immune-like cells against infection

⬇ DOWNLOAD NOW
Kalau muncul iklan pop-up, tutup lalu klik tombol kembali
Download lagu Persistent Methicillin-Resistant Staphylococcus aureus Bacteremia: Host, Pathogen, an... | RTCL.TV secara gratis hanya untuk keperluan promosi. Dukung artis favorit kamu dengan membeli musik original di iTunes atau platform resmi lainnya.
 Methicillin-Resistant Staphylococcus aureus (MRSA)
Methicillin-Resistant Staphylococcus aureus (MRSA)
 Staphylococcus aureus
Staphylococcus aureus
 How Can a Staph or a MRSA Infection be Treated?
How Can a Staph or a MRSA Infection be Treated?
 ATTACKOL / ByoKleen
ATTACKOL / ByoKleen
 Staphylococcus aureus Sepsis: Crucial Tips for Clinicians
Staphylococcus aureus Sepsis: Crucial Tips for Clinicians
Immune-like cells against infection
Immune-like cells against infection
 Diseases Caused By Staphylococcus aureus @EnteMicrobialWorld #microbiology #microbes #bacteria
Diseases Caused By Staphylococcus aureus @EnteMicrobialWorld #microbiology #microbes #bacteria
 Combatting Antibiotic Resistant Bacterial Pathogens
Combatting Antibiotic Resistant Bacterial Pathogens